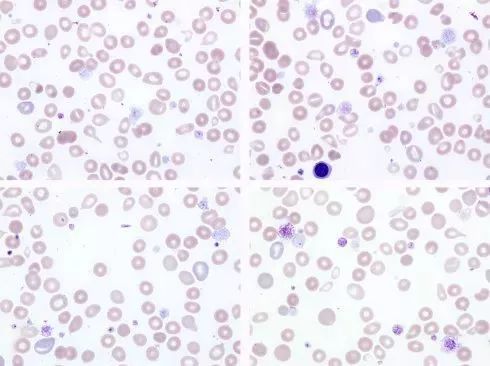
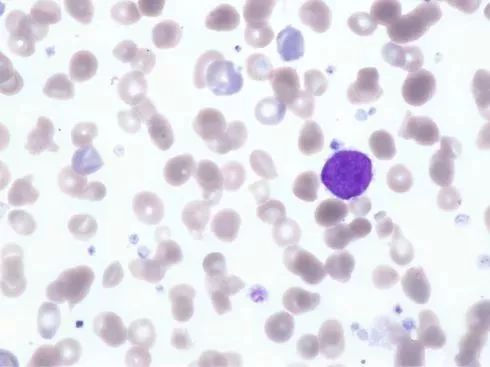

张时民教授案例分享——血小板数量正常,内物质却仿佛被掏空……
血小板数量正常就是正常吗?
大多数人可能都这样认为,但看看下面这个病例或许就不那么乐观了。

患者女,55岁,诊断为急性白血病和骨髓纤维化。
在医院治疗期间血小板数量一直浮动于(230~330)×10^9/L之间,一般认为该化疗并没有影响到血小板数量的变化。
图1显示为患者2018年8月31日血常规的血小板计数结果。看上去PLT计数正常,MPV略升高,报警提示有大血小板增多现象。

图1 患者PLT,MPV测定结果
该结果测定采用 Siemens Advia 2120血细胞分析仪,该仪器在测定PLT时采用的是激光散射法,其中低角度散射光(Y轴)表达的是血小板体积,高角度散射光(X轴)表达的是血小板内容物质。从图2看到在大血小板区域,其内容物质含量并不多,与血小板体积大小不呈正比,同时还看到大血小板增多的报警信息(L ARGE PLT +++)。

图2 Advia 2120检测PLT的散射图
再来看看血小板干物质含量(Platelet dry mass)的直方图,该方法是对血小板激光照射后,高角度散射光所反应出来的血小板内物质含量的直方图,正常人一般呈单峰的偏态分布,类似于血小板体积分布直方图。所谓干物质即指血小板内容物。图3a 为正常体检者(权且作为正常对照),图3b 为该骨髓纤维化患者。

图3 血小板物质含量直方图
可以看出骨髓纤维化患者血小板内物质含量极低,直方图未见单峰凸起,呈平缓分布形式。因此需要对血片进行观察(图4),看看血小板形态有什么样的改变。下面几幅显微镜图均为瑞姬染色,油镜观察。从这组的四张血涂片中可以看到,PLT数量未见减少,但是血小板呈大小不等,着色浅,颗粒缺失明显,甚至出现无颗粒现象。
图4 骨髓纤维化患者血涂片1
图5显示血涂片中部,红细胞密度增大,血小板体积大小正常,但多数血小板内颗粒依然缺乏。

图5 血片镜下图,血小板数量不少,但正常形态的不多
图6可见大血小板,形态不整且见颗粒缺失或无颗粒现象。

图6:大血小板,形态不整且颗粒缺失明显
图7可见血小板颗粒缺失现象,可以见到原始与幼稚细胞,这与报警信息上的提示一致。

图7 可见原始幼稚细胞
图8可见小巨核细胞,多数血小板体积大小正常,但仍然表现为颗粒缺失。
图8 小巨核细胞
图9右上可见原始细胞。该患者血片同时伴有红细胞大小不等现象。

图9:原始细胞
图10左侧可见几个颗粒分布正常的血小板,其中包括大血小板和正常血小板,可以与上面图中的血小板进行对比。整个血片中这种颗粒分布正常的血小板数量不多。

图10:正常颗粒的血小板和大血小板
根据这些表现,我们再来看看血小板的多项研究参数(图11)

图11:血小板研究参数(A为正常对照,B为该骨髓纤维化患者)
在血小板数量基本相同的情况下,该患者平均血小板体积(MPV)增大,血小板体积大小不均使得血小板体积分布宽度(PDW)同时增大,这在血涂片上已经得到证实。患者血小板压积(PCT)增高也源于血小板体积增大的因素。平均血小板内干物质含量(MPC)略低于正常对照,但其含量明显与偏大的血小板体积不符。平均血小板物质浓度(MPM)测定结果高于正常对照,其变异程度(PCDW)也高于正常对照,大血小板(Large Plt)数量则明显高于正常对照者。

在血液中,自然状态的血小板呈无色形态,具有中等强度的屈光度,呈圆盘状或椭圆状,和我们在血片上看到的形态不大一样。在涂片中正常大小的血小板直径在1~4μm,厚度为0.5~1.0μm。没有细胞核,但在光学显微镜下可以看到胞浆中含有嗜苯胺蓝颗粒;在电子显微镜下则可看到线粒体、高尔基体、溶酶体、糖原颗粒、细胞支架、致密颗粒及血小板特有的α颗粒和致密小管系统等。因此血小板内容物是一些复杂成分组合而成的物质。
当血小板被各种刺激激活之后,例如α颗粒就可以释放β-血小板球蛋白(β-TG)、血小板第3因子(PF3)、血小板第4因子(PF4)、纤维蛋白原、vWF因子;浓染颗粒也会释放二磷酸腺苷(ADP)、三磷酸腺苷(ATP)、血清素和钙离子等成分。这些成分多与凝血功能有关。
检查血小板功能的相应项目可选择:血小板聚集实验、血小板粘附试验、血小板相关免疫球蛋白(PAIg)和血小板相关补体(PA-C)测定、血小板质膜/颗粒膜糖蛋白(GP)测定、血浆β-血小板球蛋白(β-TG)和血小板第四因子(PF4)测定、血块收缩试验、凝血因子检查以及辅助凝血实验等项目,有助于筛查血小板质量缺陷及评价凝血功能,防止出凝血问题发生。
再提一问
另外,在血片观察时,见到一些血小板内有环状结构(图12),类似于红细胞内的cabot环,这里给大家呈现6幅典型图的组合。但这肯定与红细胞内的环没有关系。笔者以前没有注意过在其他血小板疾病中是否有发现,也没有关注过相应的文献报道。
这里权且将其称为血小板环,希望对此有研究的同行予以补充和解读,是否与某种疾病有关?

图12 血小板内环状结构
编辑:骆秉涵

